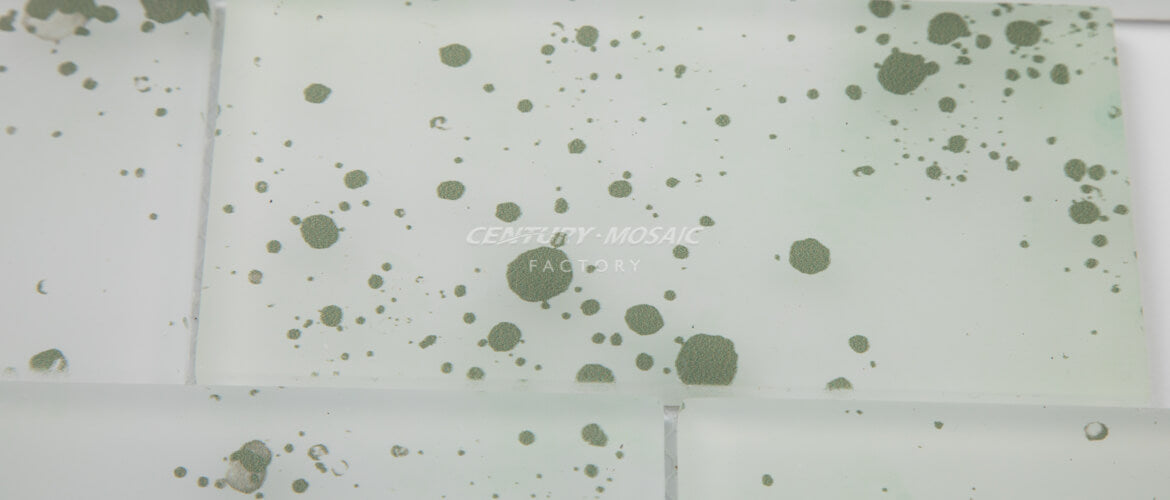

Glass Mosaic Manufacturer
Design Team Provides Customized Services
Strict Quality Control
Professional Service Team
One-stop Project Solution Services
MOQ : 300 sq.ft
10 Sheets / Box, 72 Boxes / Pallet, 28 Pallets /Container
Material : Glass
Sheet Size : 12” x 12”
Color : White
Finish Type: Glossy
Shape: Brick
Thickness :3/10”
Unit Count: Piece
Coverage: 1 sheet(0.09sqm), 1sqm(11sheets)
Usage: Suitable for kitchen backsplash, bathroom wall
Customized: Available
Sample: Available
Colorway One
SKU: CTR-GM-B20417

Colorway Two
SKU: CTR-GM-B20418

Colorway Three
SKU: CTR-GM-B20419

Colorway Four
SKU: CTR-GM-B20420